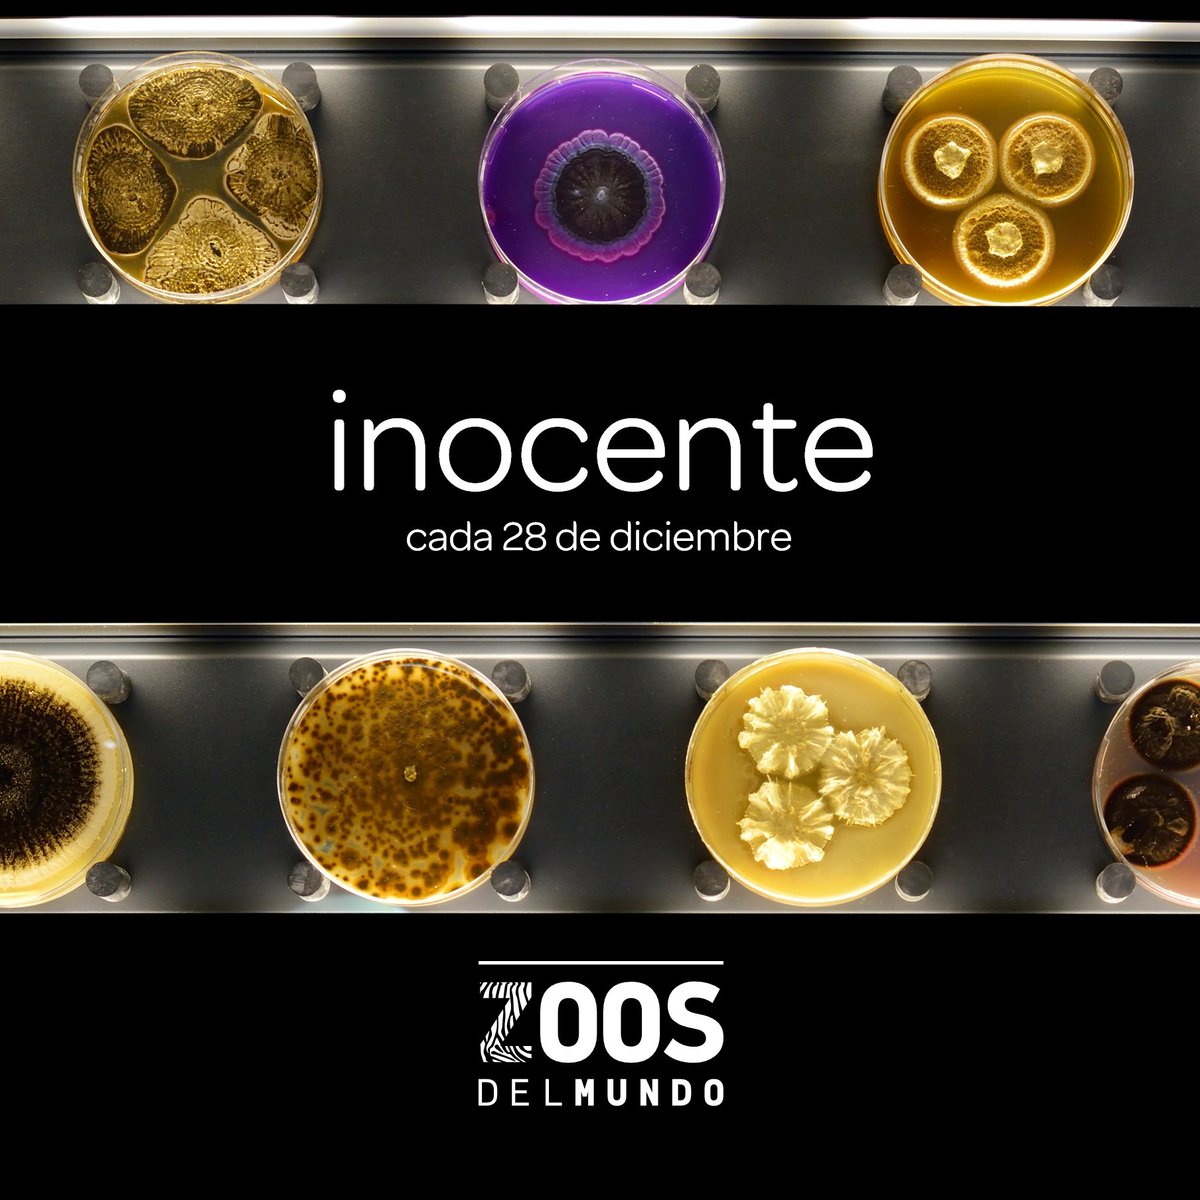
ZoosdelMundo's tweet image. ¡Era broma! 😜 Quizás pronto podamos recordar a algunos de estos virus como si fuesen piezas de museo, pero de momento es solo nuestra #inocentada de este año. Esperamos que, aunque no hayas caído en ella (¡cada año estáis más entrenados!), te hayamos podido sacar una sonrisa! 🙃

Zoos del Mundo
@ZoosdelMundo
¡Los zoos son todo un mundo! 🌍 ¡Síguenos y descubre todo lo que ocurre dentro y fuera de ellos! 🦚 ¡También en Instagram y Facebook! 👇🏻
You might like
🔴 Clearwater Aquarium comunica la muerte de Winter, una hembra de delfín mular rescatada en 2005 y que alcanzó fama internacional al ser portadora de una cola prostética. Winter, de 16 años de edad, padecía problemas gastrointestinales desde el pasado 1 de noviembre.
With heavy hearts, CMA announced tonight that Winter the Dolphin died at approximately 8 p.m. as animal care experts from around the country worked to treat her gastrointestinal abnormality. The CMA family is devastated. Read more: bit.ly/3BZfcUd

🔴 Cierre preventivo de Selwo Aventura por su proximidad a los incendios forestales que afectan a la #SierraBermeja de la provincia de #Málaga.
With heavy hearts, CMA announced tonight that Winter the Dolphin died at approximately 8 p.m. as animal care experts from around the country worked to treat her gastrointestinal abnormality. The CMA family is devastated. Read more: bit.ly/3BZfcUd

🔴 #ÚLTIMAHORA: El Zoo Aquarium de Madrid anuncia el nacimiento de dos crías de panda gigante. Son els sexto y séptimo cachorro de panda nacido en el parque desde 2010, cuando Hua Zui Ba también dió a luz a gemelos.

With heavy hearts, CMA announced tonight that Winter the Dolphin died at approximately 8 p.m. as animal care experts from around the country worked to treat her gastrointestinal abnormality. The CMA family is devastated. Read more: bit.ly/3BZfcUd

🔴 @LoroParque comunica la muerte de la orca Skyla. Su estado de salud se deterioró de forma repentina durante la pasada madrugada y el equipo veterinario no logró salvar su vida. Skyla llegó a #LoroParque en 2006, procedente de @SeaWorld San Diego.

🔵 La muerte de Shirley en @ElephantsTN —a sus excepcionales 72 años de edad— deja tras de sí una biografía convulsa que refleja la trágica vida de muchos elefantes durante el pasado siglo XX. 📖🐘 Os invitamos a leerla en el tweet citado. 👇🏻

The Elephant Sanctuary in Tennessee is deeply saddened to announce the passing of Asian elephant, Shirley, at age 72. Please join us in celebrating Shirley and her long and courageous life. bit.ly/2NXKE1x
Triste día para la familia de Cabárceno. D.E.P compañero bit.ly/2NS5WOa

🔴 #ÚLTIMAHORA: Fallece un trabajador de @PCabarceno tras ser golpeado por un elefante. El empleado era un especialista en el cuidado de los elefantes con más de 20 años de experiencia en el Parque de la Naturaleza de #Cabárceno. 📷 Parque de la Naturaleza de Cabárceno

🔴 Graves consecuencias del temporal #Filomena en el centro de recuperación de rapaces nocturnas #Brinzal, situado en la Casa de Campo de Madrid. Se cuentan animales desaparecidos y múltiples instalaciones destruidas por la acumulación de nieve.
The Elephant Sanctuary in Tennessee is deeply saddened to announce the passing of Asian elephant, Shirley, at age 72. Please join us in celebrating Shirley and her long and courageous life. bit.ly/2NXKE1x
¡Era broma! 😜 Quizás pronto podamos recordar a algunos de estos virus como si fuesen piezas de museo, pero de momento es solo nuestra #inocentada de este año. Esperamos que, aunque no hayas caído en ella (¡cada año estáis más entrenados!), te hayamos podido sacar una sonrisa! 🙃
🔴 El museo @Micropia de Ámsterdam abrirá el próximo año con la exposición temporal #Pandemic. En ella, los visitantes podrán conocer y observar ejemplares vivos del virus de la #COVID19 y especies extintas en libertad como el virus de la viruela.

Today, on the 35th anniversary of Dian Fossey’s death, we recognize the immeasurable impact that she had on gorilla conservation. Today the Fossey Fund team continues her work 365 days a year, but we need your support fosseyfund.salsalabs.org/GeneralDonatec…

United States Trends
- 1. Panarin N/A
- 2. Wizards N/A
- 3. Drury N/A
- 4. Overwatch N/A
- 5. McCain N/A
- 6. Lonzo N/A
- 7. Chris Paul N/A
- 8. Anthony Davis N/A
- 9. Mavs N/A
- 10. Luka N/A
- 11. Rangers N/A
- 12. WaPo N/A
- 13. Gavin McKenna N/A
- 14. Washington Post N/A
- 15. Greentree N/A
- 16. Trae N/A
- 17. Bezos N/A
- 18. Kings N/A
- 19. Coby N/A
- 20. Maxx N/A
You might like
-
 AZA
AZA
@zoos_aquariums -
 Bioparc Fuengirola
Bioparc Fuengirola
@BioparcF -
 Terra Natura Benidorm
Terra Natura Benidorm
@TerraNaturaZoo -
 FT Partner Content
FT Partner Content
@ft_content -
 César Favacho ~ Inseto e outros bichinhos 🐜🦗🪲🪳
César Favacho ~ Inseto e outros bichinhos 🐜🦗🪲🪳
@CesarFavacho -
 bea almeida 🦀
bea almeida 🦀
@_ohcrab -
 Radio Taiwan International
Radio Taiwan International
@RadioTaiwan_Eng -
 sally 🌙
sally 🌙
@sarasvnt -
 Ben Bartenstein
Ben Bartenstein
@BenBartenstein -
 Radio Vitoria
Radio Vitoria
@radio_vitoria -
 ZOO DE SANTILLANA
ZOO DE SANTILLANA
@ZOODESANTILLANA -
 Pol Carrasco
Pol Carrasco
@PolCa98 -
 Stephen Gibbs
Stephen Gibbs
@STHGibbs -
 Lorenda Reddekopp
Lorenda Reddekopp
@CBCLorenda -
 ZOO KOKI
ZOO KOKI
@zookoki
Something went wrong.
Something went wrong.
































































































































